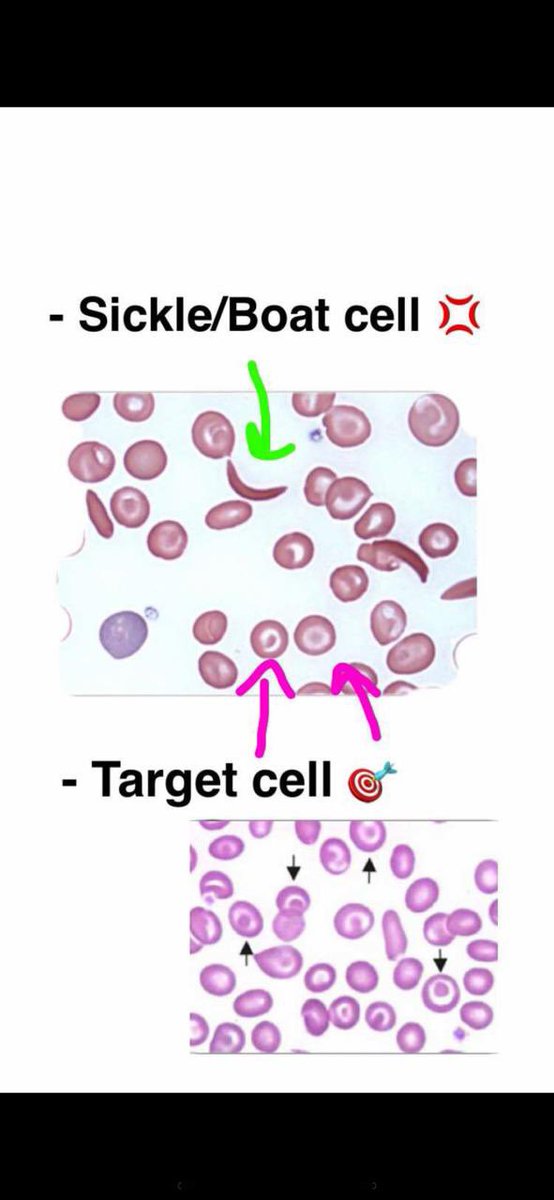

Sickle cell anemia🩸
هو أحد أنواع فقر الدم الأكثر شيوعاً 🌎و هو مرض وراثي يصيب خلايا الدم الحمراء فيغير شكلها من كروي دائري 🔴الى شكل قمري هلالي أو شكل المنجل 🌙
هو أحد أنواع فقر الدم الأكثر شيوعاً 🌎و هو مرض وراثي يصيب خلايا الدم الحمراء فيغير شكلها من كروي دائري 🔴الى شكل قمري هلالي أو شكل المنجل 🌙
وتعيش خلايا الدم الحمراء لمدة 120 يومًا قبل أن يحتاج الجسم لإستبدالها، لكن الخلايا المنجلية تموت عادة خلال 10-20 يوماً، ما يولد نقصاً في خلايا الدم الحمراء ويسبب فقر الدم⬇️
و الهيموغلوبين HB يحتوي على ✌🏻:
2 جلوبين الفا .. من كروموسوم الـ16
2 جلوبين بيتا .. كروموسوم الـ 11
2 جلوبين الفا .. من كروموسوم الـ16
2 جلوبين بيتا .. كروموسوم الـ 11
بالنسبة لكريات الدم المنجليه 🌙
تحوي الكريات الحمراء المنجلية على شكل غير طبيعي من الهيموغلوبين يسمى 💢:
📌الهيموغلوبين المنجلي (Sickle hemoglobin)
تحدث الإصابة بالإنيميا المنجلية نتيجة خلل في الجين المسؤول عن تكوين الهيموجلوبين بالجسم
تحوي الكريات الحمراء المنجلية على شكل غير طبيعي من الهيموغلوبين يسمى 💢:
📌الهيموغلوبين المنجلي (Sickle hemoglobin)
تحدث الإصابة بالإنيميا المنجلية نتيجة خلل في الجين المسؤول عن تكوين الهيموجلوبين بالجسم
📌 الهيموغلوبين (hemoglobin S/ Hb S )
الخلل الذي يطرأ على خلايا الدم الحمراء هو بسبب تبديل الحمض الأميني 2 في الموضع 6 من سلسة بيتا⛓
يتغير البروتين الطبيعي 🔁
الغلومانين glutamic acid ⬅️ فايلين valine
و هذا البروتين يسبب تطور الخلايا المنجليه 🌙
الخلل الذي يطرأ على خلايا الدم الحمراء هو بسبب تبديل الحمض الأميني 2 في الموضع 6 من سلسة بيتا⛓
يتغير البروتين الطبيعي 🔁
الغلومانين glutamic acid ⬅️ فايلين valine
و هذا البروتين يسبب تطور الخلايا المنجليه 🌙
الكريات المنجلية معروف بكونها لزجة وقاسية، فهذه الخلايا تلتصق ببعضها البعض مما يتسبب بالتصاقها بجدار الأوعية الدموية و يسبب الم و ضرر كبير 🤒
2️⃣ أثر فقر الدم المنجلي - Sickle cell trait :
➖ حامل للمرض يرث الشخص جين مصاب من احد الطرفين من طرف واحد Hb AS و هم يملكون سمة المرض فقط (أي مورثة واحدة من المرض)
➖ حاملي المرض ليس لديهم أية أعراض للمرض فقط تكون الخطورة اذا تزوج من شخص حامل للمرض أيضاً فقد يست
➖ حامل للمرض يرث الشخص جين مصاب من احد الطرفين من طرف واحد Hb AS و هم يملكون سمة المرض فقط (أي مورثة واحدة من المرض)
➖ حاملي المرض ليس لديهم أية أعراض للمرض فقط تكون الخطورة اذا تزوج من شخص حامل للمرض أيضاً فقد يست
🧐مثل ما قلنا قبل هو عباره عن طفرة جينيه 🧬
📍وين يكون ؟ في جين B جلوبين، ٦ وضع
↩️شو يسبب ؟ تغير حمض الجلوتاميك بالفالين
🧐 What?
Point mutation
📍 Where ?
B-globin gene, 6th position
↪️Results?
substitution of glutamic acid to valine in the
📍وين يكون ؟ في جين B جلوبين، ٦ وضع
↩️شو يسبب ؟ تغير حمض الجلوتاميك بالفالين
🧐 What?
Point mutation
📍 Where ?
B-globin gene, 6th position
↪️Results?
substitution of glutamic acid to valine in the
الأعراض 📋 :
🔹 Jaundice
يرقان و إصفرار البشرة و العين 🟡👀
🔹Severe anemia
فقر الدم الشديد ⬇️🩸
🔹 Hepatosplenomegaly
تضخم الكبد والطحال غالبا في المرضى الصغار
🔹 Vision problems
مشاكل في النظر 👀
🔹Blood Inflammation
التهاب الدم 🦠
🔹 Jaundice
يرقان و إصفرار البشرة و العين 🟡👀
🔹Severe anemia
فقر الدم الشديد ⬇️🩸
🔹 Hepatosplenomegaly
تضخم الكبد والطحال غالبا في المرضى الصغار
🔹 Vision problems
مشاكل في النظر 👀
🔹Blood Inflammation
التهاب الدم 🦠
🔹Skull bossing : bones of the skull become bigger than normal
عظام الجمجمة تصبح أكبر من المعتاد
🔹Dactylics (hand-foot syndrome)
التهاب الأصابع ( متلازمه اليد و القدم ) 🖐🏻
🔹Leg ulcers
قرحة الساق 🦵
عظام الجمجمة تصبح أكبر من المعتاد
🔹Dactylics (hand-foot syndrome)
التهاب الأصابع ( متلازمه اليد و القدم ) 🖐🏻
🔹Leg ulcers
قرحة الساق 🦵
🖋المضاعفات المحتملة لفقر الدم المنجلي ؟
🔹 Stroke
السكتة الدماغية 🧠
🔹 Acute chest syndrome
متلازمة الصدر الحادة
🔹 Pulmonary hypertension TOP
ارتفاع ضغط الدم الرئوي 🫀
🔹Organ damage
تلف الأعضاء
🔹 Stroke
السكتة الدماغية 🧠
🔹 Acute chest syndrome
متلازمة الصدر الحادة
🔹 Pulmonary hypertension TOP
ارتفاع ضغط الدم الرئوي 🫀
🔹Organ damage
تلف الأعضاء
🔹 Blindness
العمى - فقدان البصر 😑
🔹 Skin ulcers
تقرحات الجلد 🤚🏻
🔹 Gallstones
حصى في المرارة 🪨
العمى - فقدان البصر 😑
🔹 Skin ulcers
تقرحات الجلد 🤚🏻
🔹 Gallstones
حصى في المرارة 🪨
💊العلاجات والأدوية الداعمة التي من الممكن أن تساعد في تخفيف الألم :-
🟩 Antibiotics Folic acid Hydration Intravenous normal saline to treat Vaso occlusive crisis.
مضادات الوريد الملحي الطبيعي لعلاج أزمة انسداد الأوعيه
🟩 Blood transfusions
نقل الدم
🟩 Antibiotics Folic acid Hydration Intravenous normal saline to treat Vaso occlusive crisis.
مضادات الوريد الملحي الطبيعي لعلاج أزمة انسداد الأوعيه
🟩 Blood transfusions
نقل الدم
🟩 Hydroxyurea drugs used to reduce the effects of Hb S, OR may help produce more
Hb F ( protects against the effects of Hb S)
قد تساعد عقاقير هيدروكسي يوريا المستخدمة لتقليل تأثيرات Hb S ، أو في إنتاج المزيد
Hb F (يقي من تأثيرات Hb S)
Hb F ( protects against the effects of Hb S)
قد تساعد عقاقير هيدروكسي يوريا المستخدمة لتقليل تأثيرات Hb S ، أو في إنتاج المزيد
Hb F (يقي من تأثيرات Hb S)
🟩 Bone marrow transplant
زرع نخاع العظم يعتبر العلاج الوحيد و النهائي المحتمل لفقر الدم المنج
زرع نخاع العظم يعتبر العلاج الوحيد و النهائي المحتمل لفقر الدم المنج
@Z_al7osanii22
يعطيك العافية ع مجهودك الاكثر من رائع 🙏🏽😍
يعطيك العافية ع مجهودك الاكثر من رائع 🙏🏽😍
جاري تحميل الاقتراحات...